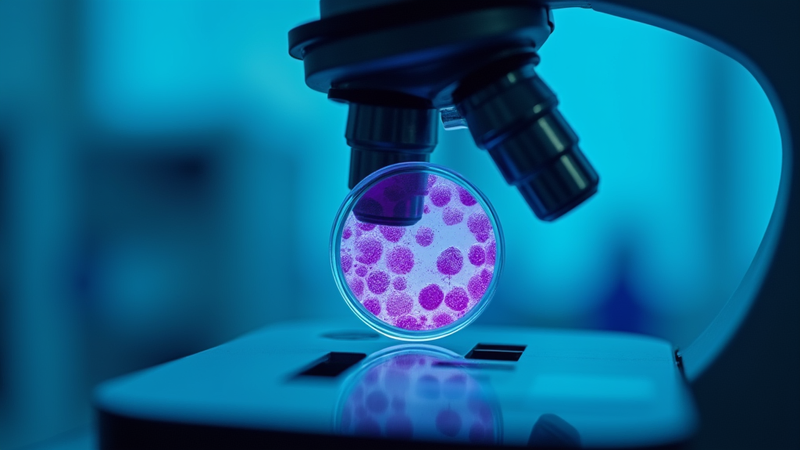

top of page
RPIHE Foundation is proud to announce that registrations are now open for our Evidence-Based Post-Doctoral Fellowship (PDF) Research Program - 2026. This program is meticulously designed for scholars dedicated to pushing the boundaries of knowledge and contributing to global Research and Development (R&D).

Established Under Not-for-Profit Organization 1882 Act, Govr. of India
bottom of page